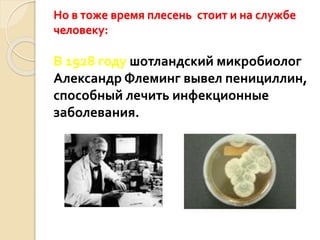
Но в тоже время плесень стоит и на службе
человеку:
В 1928 году шотландский микробиолог
Александр Флеминг вывел пенициллин,
способный лечить инфекционные
заболевания.

Документ представляет собой исследовательский проект ученика 3 класса, посвященный плесени, как живому организму и ее влиянию на человека. В проекте рассматриваются особенности строения, размножения и условий роста плесени, а также негативные и позитивные эффекты на здоровье. Результаты экспериментов подтвердили, что плесень относится к царству грибов и имеет как отрицательное, так и положительное влияние на человека.